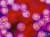
Morbillivirus morbilorum

- Какво представлява дребната шарка?
- Как мога да се заразя с морбили?
- Какъв е имунитетът при дребна шарка?
- Рискови фактори за заразяване с вируса на морбили
- Какви са симптомите на дребната шарка?
- Какви са усложненията при морбили?
- Как се поставя диагнозата дребна шарка?
- Кога да потърсим медицинска помощ при дребна шарка?
- Какво е лечението при дребна шарка?
- Трябва ли да се имунизират децата срещу морбили?
9. Какво е лечението при дребна шарка?
Липсва разработено специфично и етиологично лечение при морбили, поради което профилактиката с активни имунизационни програми играе толкова голяма роля за превенция на болестта.
Леките форми на морбили подлежат на симптоматично лечение в домашни условия, докато при тежките и особено при усложнените случаи се налага хоспитализация и предприемане на насочени мерки за стабилизиране на пациентите и предотвратяване по-тежки и дългосрочни увреждания и последици.
9.1. Общи принципи в лечението на морбили

Липсата на разработено и налично към момента етиологично (насочено към причинителя) лечение на морбили, разликите в протичането при отделните възрастови групи и рискови популации, е причина за наличието на някои основни принципи в терапията на морбили, касаещи необходимостта от хоспитализация и изолация на пациентите:
- лечение в домашни условия: при леките и средно тежките форми на заболяването лечението може да се проведе успешно в домашни условия, като следва да бъдат информирани пациентите (или техните родители) за алармиращите симптоми, за които трябва да следят и които насочват към развитие на усложнения, изискващи хоспитализация
- хоспитализиране на пациентите: при тежките форми на дребна шарка, свързани с усложнения, както и при имунокомпрометирани пациенти, се налага хоспитализация и лечение в болница. Болничното лечение при дребна шарка в инфекциозно отделение се налага и при деца под две годишна възраст, при деца, живеещи в лоши битови условия, при рискова бременност и други по преценка на лекуващия лекар
- изолация на болните: болните от дребна шарка трябва да се изолират и да имат възможно най-малък и кратък контакт с други хора. Болните деца не трябва да посещават училище или детска градина поне 5 дни след появата на обрива. При настъпили усложнения трябва да се изолират с контакт от други деца до 10 дни
9.2. Симптоматично лечение при морбили

Основното лечение при морбили, особено при леките и умерени форми на заболяването, се състои в приложение на симптоматични средства за подобряване комфорта на пациентите, облекчаване на оплакванията и ускоряване на възстановителните процеси. Сред едни от най-често назначаваните симптоматични средства се включват:
- антипиретици: при бебета и малки деца с най-добър ефект и профил на безопасност са препаратите, съдържащи парацетамол и ибупрофен, приложени обикновено под формата на сироп, ректални свещички, прахчета за разтваряне във вода. Аспирин не се препоръчва при малки деца и подрастващи във връзка с рисковете от развитие на синдром на Reye и свързаните с него чернодробни и неврологични усложнения. При лица в активна и напреднала възраст могат да се използват широка гама лекарства с антипиретична активност
- противовъзпалителни средства: с повишено внимание се използват някои представители от групата на нестероидните противовъзпалителни средства, като е необходимо съобразяване на дозата, дозовия режим и продължителността на лечение с възрастта и общото състояние на засегнатите
- препарати за лечение на кашлицата: при малки деца се назначават препарати на растителна основна, докато при възрастни могат да се назначат подходящи антитусивни средства за облекчаване на кашлицата
- адекватна хидратация: особено при бебета и малки деца е изключително важно проследяването на ежедневните количества приемани течности с цел намаляване риска от обезводняване. Рискът от дехидратация нараства при наличие на диария или повръщане
- пълноценна диета: пълноценното хранене и балансирана диета са важна част от комплексното лечение, като е необходимо съобразяване с наличието на подлежащи гастроинтестинални оплаквания, лезии в устната кухина и други
- осигуряване на почивка: пациентите, независимо от възрастта, в катаралния и обривния стадий имат нужда от активна почивка, покой и достатъчно сън
- прием на витамини и минерали: при потвърден дефицит или недостиг на витамин А е уместно стартирането на суплементираща терапия след консултация със специалист. В общия случай могат да бъдат назначени комбинирани препарати, съдържащи необходимите ежедневни количества витамини и минерали за съответната възраст
9.3. Лечение на усложненията при морбили

При данни за развитие на усложнения е необходимо своевременно хоспитализиране на пациентите, назначаване на съответните изследвания за уточняване на наличните увреждания и изготвяне на индивидуален терапевтичен план с цел тяхното бързо повлияване и стабилизиране на пациентите:
- лечение на инфекциозните усложнения: бактериалните усложнения при дребна шарка, като инфекция на средното ухо (отит), бронхит, пневмония, плевропневмония, менингит, трябва да се лекуват с подходящи антибиотици и химиотерапевтици, съобразно резултатите от антибиограмата, в дозов режим, съобразен с възрастта и особеностите на конкретния пациент
- лечение на неврологичните усложнения: при наличие на неврологични усложнения може да се наложи провеждане на медикаментозна терапия с антиконвулсивни средства, седативни препарати, подходящи кортикостероиди и други
- лечение на зрителните усложнения: при данни за засягане на очите в хода на инфекцията с морбили е необходимо своевременно стартиране на специфично и целенасочено лечение с очни капки, системни препарати и други средства
- други: в зависимост от съответните усложнения се назначават спешни реанимационни мерки, средства за корекция на водно-електролитния баланс, алаклано-киселинното равновесие, стомашно-чревните нарушения и други

Коментари към Морбили (дребна шарка)